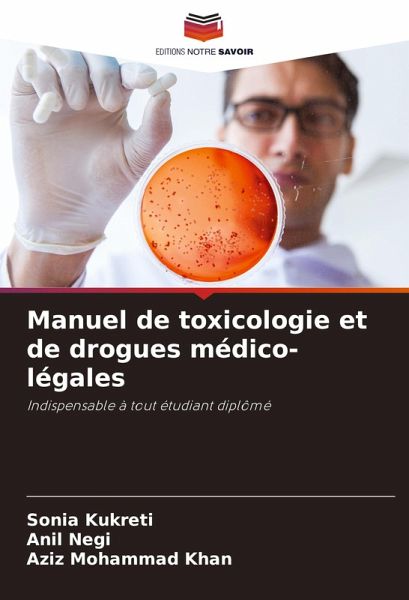
Manuel de toxicologie et de drogues médico-légales

Manuel de toxicologie et de drogues médico-légales
Indispensable à tout étudiant diplômé
Versandkostenfrei!
Versandfertig in 6-10 Tagen
29,99 €
inkl. MwSt.
PAYBACK Punkte
15 °P sammeln!
Ce manuel a pour but d'enseigner les principes fondamentaux de la toxicologie et de la pharmacie médico-légale aux étudiants indiens de premier cycle en médecine. Il s'agit d'un vaste travail d'amour qui vise à présenter le sujet de la manière la plus méthodique et la plus structurée possible. L'objectif est de rechercher dans les moindres détails les signes d'abus de drogues et de polluants. Toutes les rubriques du chapitre de base sur la médecine légale et la toxicologie sont clairement divisées en sous-thèmes et sous-rubriques.